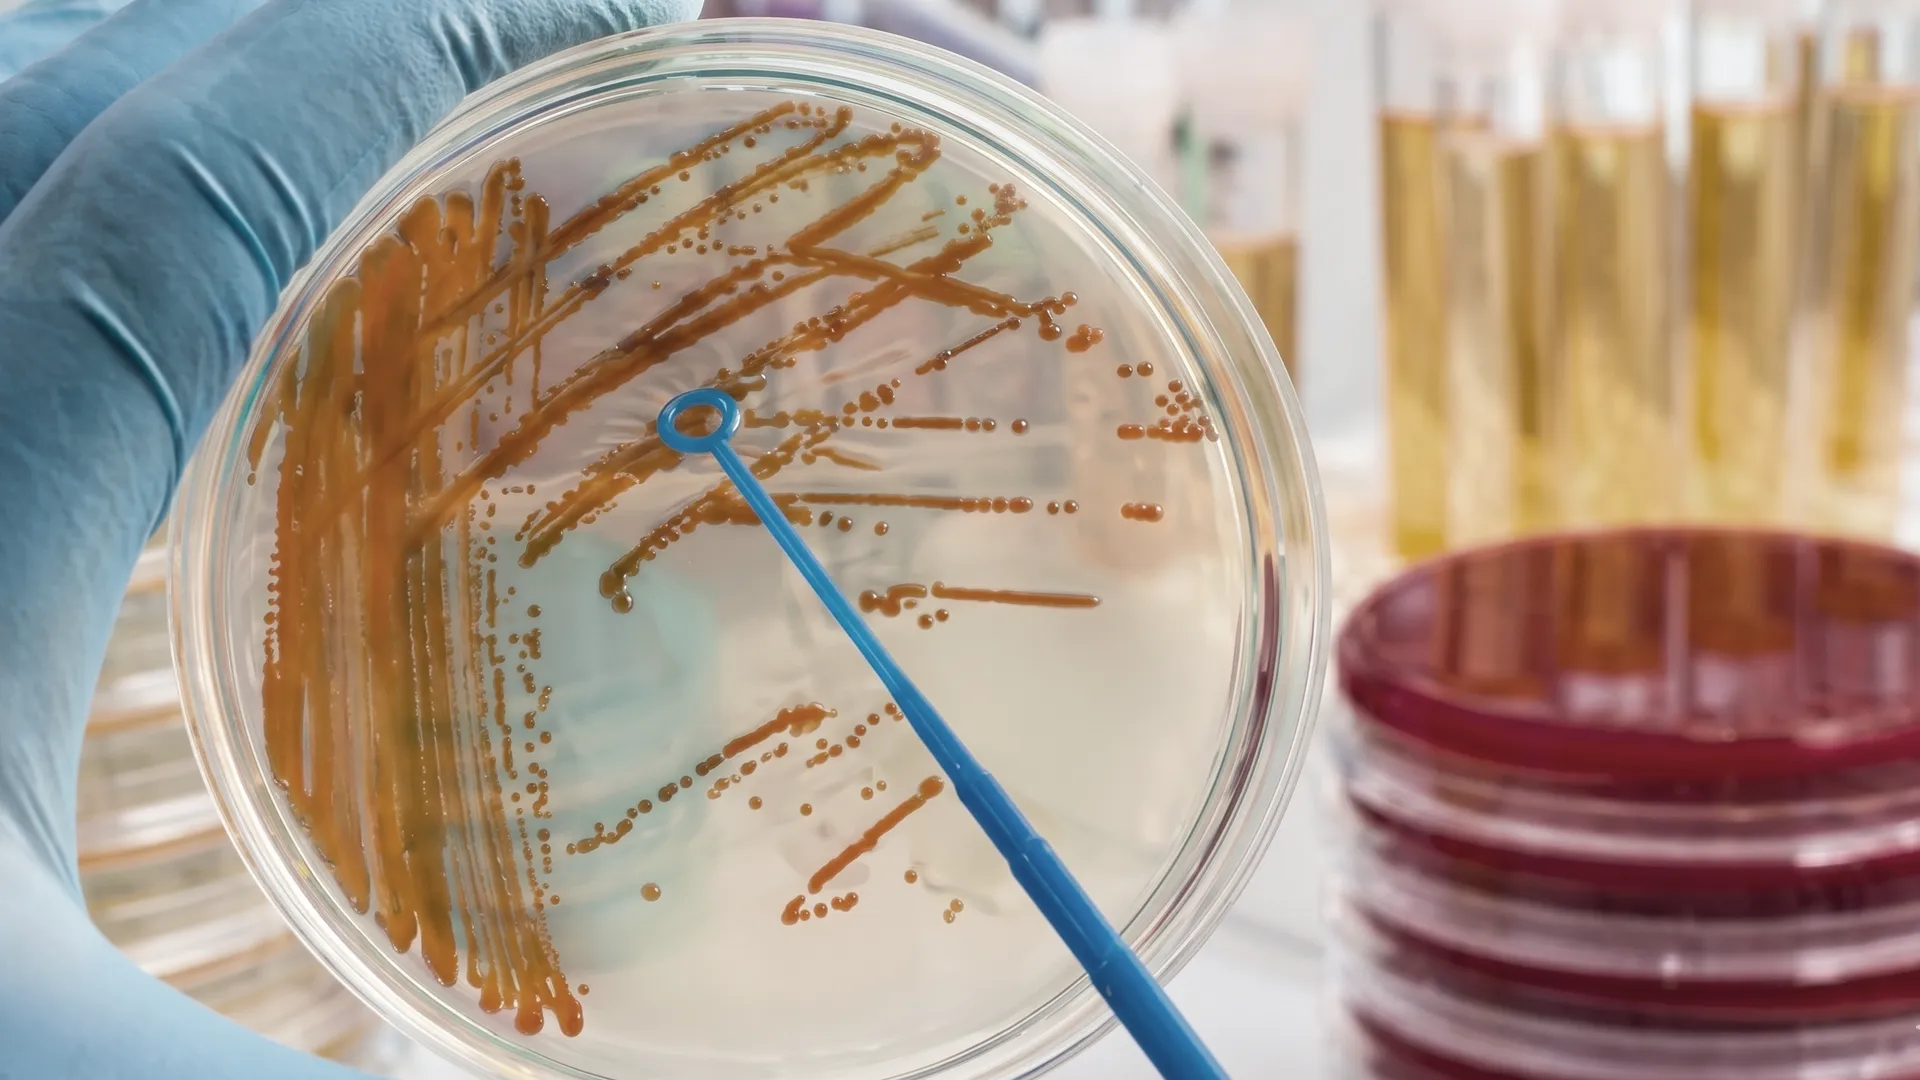

CF · JUNGHUN Urology Clinic
단순포진 (Herpes Simplex Virus)
일상 속 단순포진
예방은 신속한조기 치료를 통해 시작됩니다.
단순포진은 단순포진바이러스(HSV)에 의해 발생하는 감염 질환으로, 피부나 점막에 물집·통증·가려움 등을 유발합니다.입 주위(HSV-1) 또는 생식기(HSV-2)에 주로 나타나며, 전염성이 높습니다.피로·스트레스·면역 저하 시 재발할 수 있어 관리가 중요합니다.

단순포진의 원인
단순포진의 원인은 단순포진바이러스(HSV-1, HSV-2) 감염입니다.HSV-1은 주로 구강·입술 부위, HSV-2는 성접촉을 통해 생식기 부위에 감염됩니다.한 번 감염되면 바이러스가 신경절에 잠복하여 재활성화될 수 있습니다.
※ 단순포진은 HSV 감염으로 발생하며, 면역 저하·스트레스가 재발의 주요 원인입니다.
단순포진의 증상
Symptoms of Herpes Simplex Virus
단순포진의 대표적인 증상은 물집과 통증, 작열감입니다.재발 시 가벼운 따가움·가려움이 동반될 수 있습니다.
※ 단순포진은 물집·통증·가려움 등으로 나타나며, 면역 상태에 따라 증상이 달라집니다.
피부·점막에 물집, 따가움, 작열감
입술 또는 성기 주변 통증과 가려움
물집이 터지며 진물과 딱지 형성
발열, 피로, 근육통 등 전신 증상
성교 시 통증, 배뇨통 동반 가능
재발 시 가벼운 통증 또는 따가움으로 시작
단순포진의 치료
단순포진 치료는 항바이러스제를 통해 증상 기간을 단축하고 전파를 방지합니다.초기 감염 시에는 항바이러스제 복용이 효과적이며, 재발이 잦은 경우 예방적 요법을 시행합니다.수포 부위는 청결히 유지하고, 손으로 만지지 않도록 주의해야 합니다.CF · 정훈비뇨기과에서는 구강·생식기 포진 모두에 대한 정밀검사와 맞춤 치료를 제공합니다.
※ 항바이러스제는 증상 초기에 복용해야 효과적이며, 재발 시 전문의 상담이 필요합니다.
단순포진은 누구에게나 발생할 수 있지만,
일상 속 작은 습관들로 충분히 예방할 수 있는 질환입니다.
단순포진을 예방하기 위해서는 감염자의 병변 접촉을 피하고, 피로와 스트레스를 줄여 면역력을 유지하는 것이 중요합니다.성접촉 시 콘돔을 사용하고, 증상 발생 시 성관계를 피하세요.개인용품(수건, 립밤 등)을 따로 사용하는 것도 도움이 됩니다.
* 단순포진은 완치가 어려운 만성 감염 질환이지만, 조기 치료로 재발과 전파를 줄일 수 있습니다. 증상이 있을 때는 전문의 진료를 받으세요.
CF · JUNGHUN Urology Clinic
단순포진 (Herpes Simplex Virus)
일상 속 단순포진
예방은 신속한조기 치료를 통해 시작됩니다.
단순포진은 단순포진바이러스(HSV)에 의해 발생하는 피부 및 점막 감염 질환입니다.입술(HSV-1) 또는 생식기(HSV-2)에 주로 생기며, 통증과 물집이 특징입니다.면역력이 떨어지면 재발할 수 있으므로 조기 치료가 중요합니다.

단순포진의 원인
단순포진의 원인은 HSV-1(구강)과 HSV-2(생식기) 감염입니다.감염자의 침, 체액, 병변 부위 접촉으로 전파되며, 감염 후 신경절에 잠복해 있다가 피로·스트레스·면역저하 시 재활성화됩니다.
※ 단순포진은 HSV 감염으로 발생하며, 면역 저하·스트레스가 재발의 주요 원인입니다.






단순포진의 증상
Symptoms of Herpes Simplex Virus
단순포진의 대표적인 증상은 물집과 통증, 작열감입니다.재발 시 가벼운 따가움·가려움이 동반될 수 있습니다.
※ 단순포진은 물집·통증·가려움 등으로 나타나며, 면역 상태에 따라 증상이 달라집니다.
피부나 점막에 물집과 따가움·통증
입술 또는 생식기 주변의 작열감·가려움
물집이 터지며 진물과 딱지 형성
발열, 피로감 등 전신 증상
성교 시 통증·배뇨통 동반 가능
재발 시 따가움 또는 미열 동반
단순포진의 치료
단순포진은 항바이러스제 복용을 통해 증상 기간을 단축하고 재발을 억제할 수 있습니다.수포 부위는 청결하게 유지하고, 손으로 만지지 않도록 주의합니다.재발이 잦다면 예방적 항바이러스 요법을 시행할 수 있습니다.
※ 항바이러스제는 증상 초기에 복용해야 효과적이며, 재발 시 전문의 상담이 필요합니다.